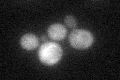
YLR144C
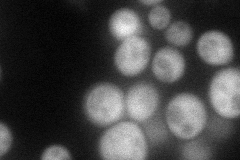
YLR144C
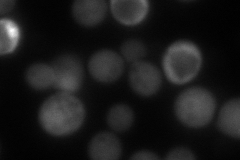
YLR144C
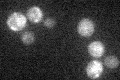
YLR144C

View description
Intracellular beta-1,3-endoglucanase, expression is induced during sporulation; may have a role in cortical actin cytoskeleton assembly
Localization:
Intensity:
Fold change:
Significance:
-
C’ GFP library in SD
cytosol29.93 -
N' NOP1pr-GFP in SD
cytosol89.9908 -
N' TEF2pr-mCherry in SD
cytosol94.7346 -
N' NATIVEpr-GFP in SD

nucleus29.3197 -
N' TEF2pr-VC and Cyto-VN in SD

#N/A0 -
C’ GFP library in SD+DTT

cytosol29.680.99No -
C’ GFP library in SD+H2O2

cytosol29.550.98No -
C’ GFP library in Starvation Media
cytosol27.110.9No -
C’ GFP library on the background of Pup2-DaMP

cytosol -
C’ GFP library on the background of CCT mutant

cytosol29.56050.987273No
